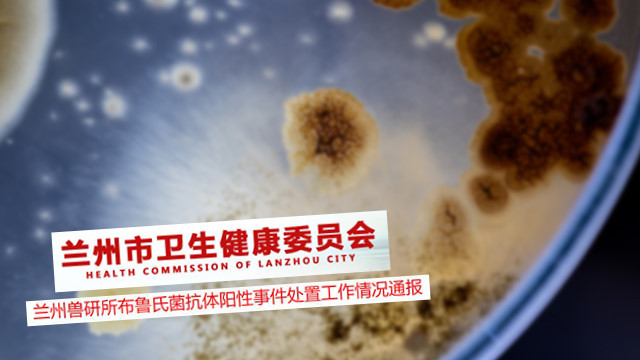

중국 서북부 간쑤성에서 브루셀라병 백신 생산공장의 부주의로 3000여 명이 브루셀라병에 집단 감염된 사실이 알려졌습니다.

또 다른 대규모 전염병 유행에 대한 우려가 커지고 있습니다.
16일 중국 매체 신경보에 따르면 지난해 12월 중국농업과학원 산하 간쑤성 란저우 수의연구소에서 브루셀라병 집단 감염이 발생하였습니다.



이후 지난 14일까지 란저우시 주민 2만 1847명을 대상으로 검사한 결과 3245명이 브루셀라병 확진 판정을 받았습니다.
브루셀라병의 확진율은 약 15%입니다.
중국 조사 당국에 따르면 이번 브루셀라병 감염은 중무 란저우생물제약공장이 지난해 7~8월 동물용 브루셀라병 백신 생산 과정에서 사용 기한이 지난 소독약을 쓰면서 발생했습니다.
소독약 문제로 발효·생산시설에서 나온 폐기물이 제대로 살균되지 않았고, 브루셀라균이 포함된 폐기물이 에어로졸 형태로 외부로 퍼졌다고 설명했습니다.



당시 이 지역에는 주로 동남풍이 불었는데, 그 방향에 위치하고 있던 연구소의 직원들과 인근 지역 주민들이 감염된 것으로 조사되었습니다.
중국은 지난 1월 문제가 된 공장의 브루셀라병 백신 생산 허가와, 다른 동물용 백신 7종의 비준을 취소했습니다.

해당 공장은 지난해 12월 7일 작업장 가동을 중단하였고, 지난 2월 회사 홈페이지를 통해 사과문을 발표하는 등 보상 작업도 진행하겠다고 밝혔습니다.
브루셀라병은 소와 양 등의 가축에서 사람으로 전염되는 인수 공통 전염병입니다.
사람이 브루셀라병에 감염되었을 경우 보통 3주의 잠복기를 거쳐 발열과 두통 등의 전신 증세가 나타나고, 남성의 고환과 여성의 난소 등 생식계통에도 영향을 미칠 수 있습니다.
효과적인 치료법이 없어, 세계보건기구(WTO)는 브루셀라병을 예방하기 위해 적극적 노력을 기울이고 있습니다.
브루셀라병은 치사율은 2% 이하지만 방치할 경우 척추염이나 골수염 등을 일으키는 것으로 알려져 있습니다.
[이슈/경제&시사&사회] - 독감 무료접종 대상, 기간 총정리
독감 무료접종 대상, 기간 총정리
질병관리본부가 9월 8일부터 국민 1,900만 명을 대상으로 독감 예방접종을 무료로 시행합니다. 신종 코로나바이러스 감염증 코로나19와 인플루엔자 바이러스의 동시 유행을 대비하기 위해서 1900��
arecareca.com
코로나 독감 차이 총정리!
코로나도 걱정인데 이젠 독감마저 걱정해야 할 계절이 돌아왔습니다. 코로나 독감 차이, 구별법에 대해서 알아보도록 하겠습니다. 코로나 증상 발현 순서는 발열부터 증상이 시작됩니다. 독감��
arecareca.com
[이슈/경제&시사&사회] - 사회적 거리두기 2단계 기준 업종별 총정리 ~9/27까지
사회적 거리두기 2단계 기준 업종별 총정리 ~9/27까지
정부가 수도권 사회적 거리두기 2단계로 하향 조정되어 9월 27일까지 실시합니다. 노래연습장, 감성주점, 클럽, 뷔페 등 고위험시설 11종의 집합금지는 유지하고 빵집, 카페 등 자영업자 운영시설
arecareca.com
'이슈 > 건강' 카테고리의 다른 글
| 빨간약 포비돈 코로나 만드는법! 총정리 (0) | 2020.09.29 |
|---|---|
| 독감 3가 4가 차이와 가격! (0) | 2020.09.24 |
| 독감 무료 예방접종 중단 이유! 고령자,유료접종은? (0) | 2020.09.22 |
| 독감 백신 무료접종 중단! 일정 변경 +이유 (0) | 2020.09.22 |
| 코로나 독감 차이 총정리! (0) | 2020.09.16 |
| 코로나 백신 확보 추진! 국민 60% 분량 (0) | 2020.09.15 |
| 코로나 항체 감염자 1440명 중 1명 보유, 집단면역 불가능! (0) | 2020.09.14 |
| 롱테일 코로나란? (0) | 2020.09.11 |
댓글